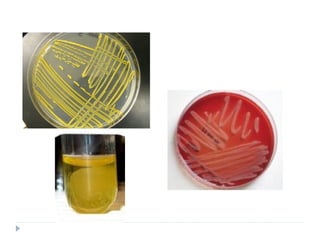

El documento describe la familia Staphylococcaceae, con énfasis en el género Staphylococcus. Staphylococcus aureus es una bacteria Gram positiva que forma racimos y es un patógeno humano común que causa infecciones supurativas. Produce diversas toxinas y enzimas que le permiten adherirse a tejidos, evadir el sistema inmune y causar enfermedades como intoxicación alimentaria y síndrome de shock tóxico. Otras especies como S. epidermidis son comensales de la piel pero también pueden caus










![Caracteres fisiológicas
Crecimiento en Gelosa
Sangre
37’C, 24h.
Pueden crecer entre
100C y 460C
Facultativo
Fermentan azúcares
Muy resistentes
Soporta altas [ ] de sal
(7.5-10%)](https://image.slidesharecdn.com/patogenesisdes-aureus28-08-12-121011185748-phpapp01/85/Patogenesis-de-s-aureus-11-320.jpg)